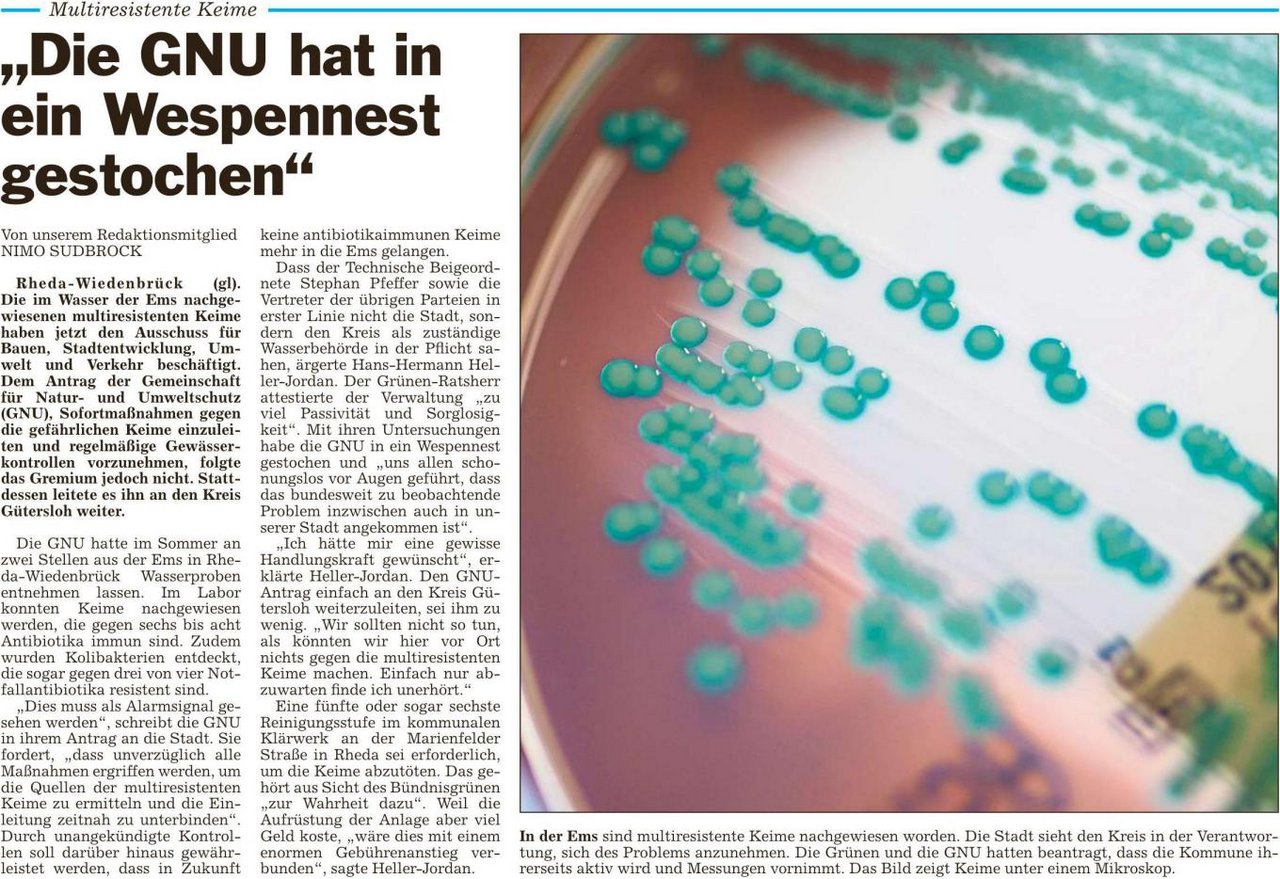

Die Glocke, 15.12.2018

Die Glocke, 13.12.2018

Neue Westfälische, 13.12.2018
Die Glocke, 23.11.2018

Die Glocke, 16.11.2018

Neue Westfälische, 26.09.2018
Die Glocke, 26.09.2018
Neue Westfälische, 18.07.2018


Neue Westfälische, 12.07.2018

Die Glocke, 12.07.2018

Die Glocke, 11.07.2018

Die Glocke, 12.05.2018

Die Glocke, 12.05.2018

Die Glocke, 10.05.2018

Neue Westfälische, 10.05.2018

Die Glocke, 22.03.2018



Neue Westfälische, 22.03.2018


Die Glocke, 17.02.2018

Westfalenblatt, 03.02.2018

Die Glocke, 03.02.2018

Neue Westfälische, 12.01.2018


Die Glocke, 06.01.2018

Neue Westfälische, 05.01.2018
